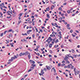

RIKEN Center for Integrative Medical Sciences Laboratory for Cancer Genomics
Team Director: Hidewaki Nakagawa (M.D., Ph.D)
Research Summary

Cancer is a disease driven by genomic abnormalities, and various molecular-targeted therapies have been developed to specifically address these abnormalities. Additionally, cancer risk prediction based on genomic mutations and polymorphisms is advancing, promoting personalized approaches in treatment, diagnosis, and prevention. As demonstrated by the success of immunotherapy, cancer is also recognized as an immune-related disease.
Our team utilizes next-generation sequencing, single-cell analysis, and spatial transcriptomics to investigate the genomics and immunology of various human diseases, including cancer and hereditary disorders. We are actively building genomic databases to elucidate the relationship between genomic alterations and disease or treatment response and conducting functional analyses to assess their biological, immunological, and clinical significance.
Furthermore, we participate in the development of global genomic databases, such as those managed by the International Cancer Genome Consortium (ICGC), contributing to the infrastructure for genome-based research. Our ultimate goal is to enable personalized medicine through the integration and application of genomic information.
Main Research Fields
- Medicine, Dentistry & Pharmacy
Related Research Fields
- Informatics
- Biological Sciences
- Biology
Keywords
- Cancer genomics
- Precision Medicine
- Next generation sequencer
- Cancer immunogenomics
Selected Publications
- 1.
Okawa Y, Sasagawa S, Johnson TA, Kato H, Nagaoka K, Kobayashi Y, Hayashi A, Shibayama T, Maejima K, Tanaka H, Miyano S, Shibahara J, Nishizuka SS, Hirano S, Seto Y, Iwaya T, Kakimi K, Yasuda T, and Nakagawa H.:
"Immuno-genomic analysis reveals eosinophilic feature and favorable prognosis of female non-smoking esophageal squamous cell carcinomas."
Cancer Letters. 581:216499 (2024) - 2.
Wang H, Chen L, Xue R, Lie M, Bai J, Bao J, Wang Y, Li Z, Wang W, Wang R, Zheng B, Yang A, Hu J, Lie K, Shen S, Wang Y, Zhu Y, Gu J, Gao D, Wng XW, Nakagawa H, Zang N, Wu L, Rozen SG, Bai F, and Wang H.:
"Deep whole genome analysis of 494 hepatocellular carcinomas."
Nature. 627(8004):586-593 (2024) - 3.
Okawa Y, Iwasaki Y, Johnson TA, Ebata N, Inai C, Endo M, Maejima K, Sasagawa S, Fujita M, Matsuda K, Murakami Y, Nakamura T, Hirano S, Momozawa Y and Nakagawa H.:
"Hereditary cancer variants and homologous recombination deficiency in biliary tract cancers."
J Hepatol. 78(2):333-342 (2023) - 4.
Shima Y, Sasagawa S, Ohta N, Oyama R, Sogawa C, Kim Y, Sakashita-Kubota M, Kawakami H, Naemura K, Takubo N, Kobayashi M, Ozeki A, Nakaki R, Tanaka M, Kamatani Y, Matsuda K, Kurihara H, Furihata T, Takahashi S, Rikitake Y, Kozaki K, Nakafuku M, Mataga N, Ohtsuka N, Akimitsu N, Wada Y, Kamiguchi H, Okabe S, Kato T, Nakagawa H, Saito N, and Nakatomi H.:
"Increased PDGFRB and NF-κB signaling caused by highly prevalent somatic mutations in intracranial aneurysms."
Science Trans Med. 15(700):eabq77218 (2023) - 5.
Fujita M, Chen MM, Siwak DR, Sasagawa S, Arihiro M, Arihiro K, Ono A, Miura R, Osawa-Tatsuguchi A, Maejima K, Aikata H, Ueno M, Hayami S, Yamaue H, Chayama K, Lu Y, Liang H, Nishizuka SS, and Nakagawa H.:
"Proteogenomic characterization of virus-associated liver cancers reveals potential subtypes and therapeutic targets."
Nat Commun. 13(1):6481 (2022) - 6.
Sasagawa S, Kato H, Nagaoka K, Sun C, Imano M, Sato T, Johnson TA, Fujita M, Maejima K, Okawa Y, Kakimi K, Yasuda T, and Nakagawa H.:
"Immuno-genomic profiling of biopsy specimens predicts neoadjuvant chemotherapy response in esophageal squamous cell carcinoma."
Cell Rep Med. 3(8):100705 (2022) - 7.
The ICGC/TCGA Pan-Cancer Analysis of Whole Genomes Consortium.:
"Pan-cancer analysis of whole genomes."
Nature 578(7793):82-93 (2020) - 8.
Fujimoto A, Fujita M, Maejima K, Hasegawa T, Nakano K, Oku-Sasaki A, Wong J, Shiraishi Y, Miyano S, Imoto S, Akagi T, and Nakagawa H.:
"Comprehensive analysis of indels in whole-genome microsatellite regions and microsatellite instability across 21 cancer types."
Genome Res. 30: 334-346 (2020) - 9.
Takata R, Takahashi A, Fujita M, Momozawa Y, Saunders EJ, Yamada H, Maejima K, Nakano K, Yamaji T, Sawada N, Iwasaki M, Tsugane S, Sasaki M, Shimizu A, Tanno K, Minegishi N, Suzuki K, Matsuda K, Kubo K, Inazawa J, Egawa S, Haiman CA, Ogawa O, Obara W, Kamatani Y, Akamatsu S, and Nakagawa H.:
"12 new susceptibility loci for prostate cancer identified by genome-wide association study in Japanese population."
Nat Commun. 10:4422 (2019) - 10.
Fujimoto A, Furuta M, Totoki Y, Tsunoda T, Kato M, Shiraishi Y, Tanaka H, Taniguchi H, Kawakami Y, Ueno M, Gotoh K, Ariizumi S, Wardell CP, Hayami S, Nakamura T, Aikata H, Arihiro K, Boroevich KA, Abe T, Nakano N, Maejima K, Sasaki-Oku A, Ohsawa A, Shibuya T, Nakamura H, Hama N, Hosoda F, Arai Y, Ohashi S, Urushidate T, Nagae G, Yamamoto S, Ueda H, Tatsuno K, Ojima H, Hiraoka N, Okusaka T, Kubo M, Marubashi S, Yamada T, Hirano S, Yamamoto M, Ohdan H, Shimada K, Ishikawa O, Yamaue H, Chayama K, Miyano S, Aburatani H, Shibata T, and Nakagawa H.:
"Whole genome mutational landscape and characterization of non-coding and structural mutations in liver cancer."
Nat Genet 48: 500-509 (2016)
Recent Research Results

Jul. 1, 2016
Liver cancer’s genomic landscape
Apr. 17, 2015
An infectious imprint on liver cancer
Related Links
Lab Members
Principal investigator
- Hidewaki Nakagawa
- Team Director
Core members
- Todd Andrew Johnson
- Research Scientist
- Shota Sasagawa
- Senior Research Scientist
- Kazuhiro Maejima
- Technical Staff I
- Ayako Oosawa
- Technical Staff II
- Ryosuke Jikuya
- Visiting Scientist
Contact Information
East Research Bld. 4F,
1-7-22 Suehiro-cho, Tsurumi-ku, Yokohama, Kanagawa,
230-0045, Japan
Tel: +81-(0)45-503-9288
Fax: +81-(0)45-503-9294
Email: ims-web@riken.jp
